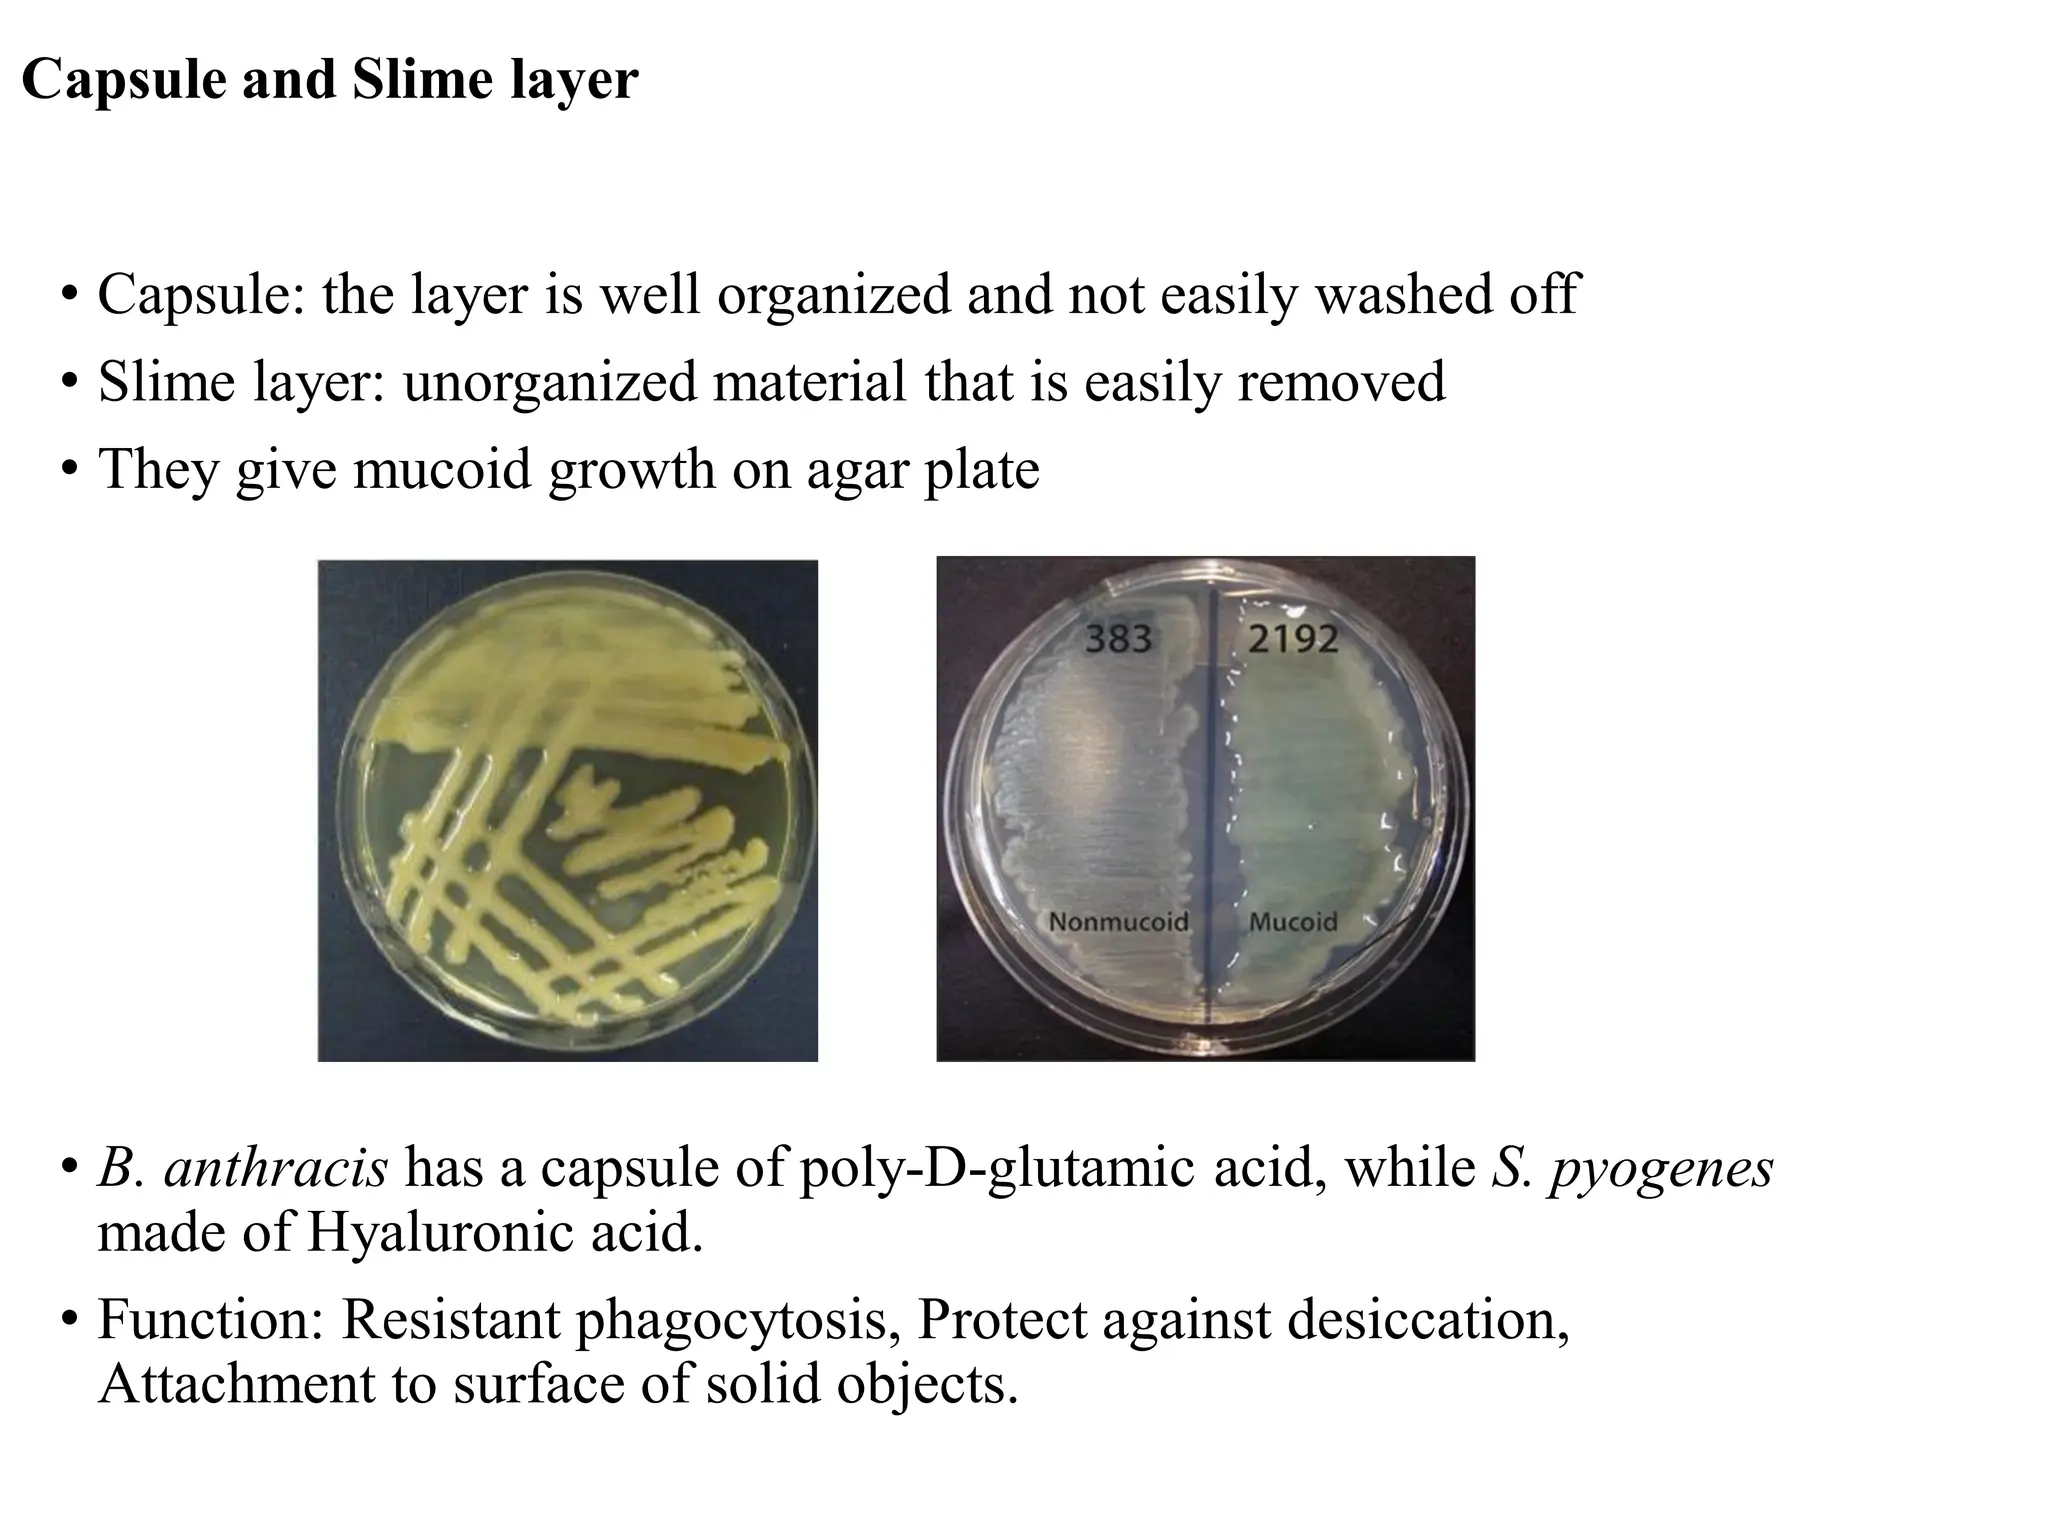
Capsule and Slime layer
• Capsule: the layer is well organized and not easily washed off
• Slime layer: unorganized material that is easily removed
• They give mucoid growth on agar plate
• B. anthracis has a capsule of poly-D-glutamic acid, while S. pyogenes
made of Hyaluronic acid.
• Function: Resistant phagocytosis, Protect against desiccation,
Attachment to surface of solid objects.

This document discusses bacterial cell structure and morphology. It describes the three basic shapes of bacteria as cocci, bacilli, and spirillum. The arrangement of bacterial cells depends on how they remain attached after cell division, forming structures like chains, clusters, or packets. The document outlines the various appendages that may be present, including flagella, fimbriae, and pili. It also describes the cell surface layers like capsules and cell walls, made of peptidoglycan consisting of sugars and peptides that provide structural integrity.